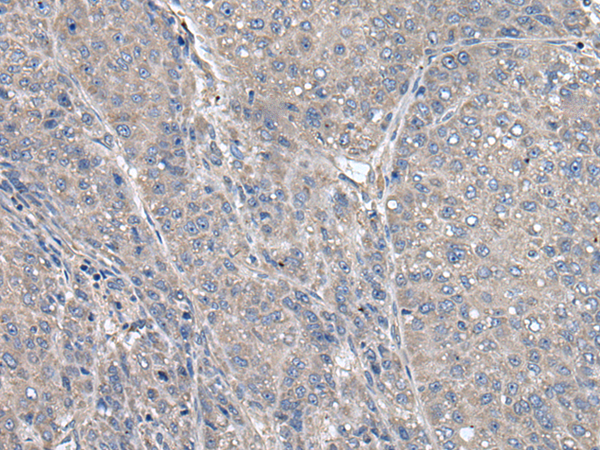

-
分类: 科研抗体货号: P08834别名:应用: WB,IHC反应种属: Human, Mouse
-
分类: 科研抗体货号: P08816别名:应用: IHC反应种属: Human
-
分类: 科研抗体货号: P08853别名:应用: IHC反应种属: Human, Mouse
-
分类: 科研抗体货号: P08833别名: FHL4; HLH4; HPLH4应用: WB,IHC反应种属: Human, Mouse
-
分类: 科研抗体货号: P08815别名: STARD1应用: WB,IHC反应种属: Human, Mouse, Rat
-
分类: 科研抗体货号: P08852别名:应用: IHC反应种属: Human
-
分类: 科研抗体货号: P08832别名: SYN10; hsyn10应用: WB,IHC反应种属: Human
-
分类: 科研抗体货号: P08814别名: STC-2; STCRP应用: IHC反应种属: Human, Mouse, Rat
-
分类: 科研抗体货号: P08851别名: EBAF; LEFTA; TGFB4; LEFTYA应用: WB,IHC反应种属: Human, Mouse
-
分类: 科研抗体货号: P08830别名: Ufe1应用: WB,IHC反应种属: Human, Mouse, Rat

鄂公网安备42018502007531号
鄂公网安备42018502007531号

